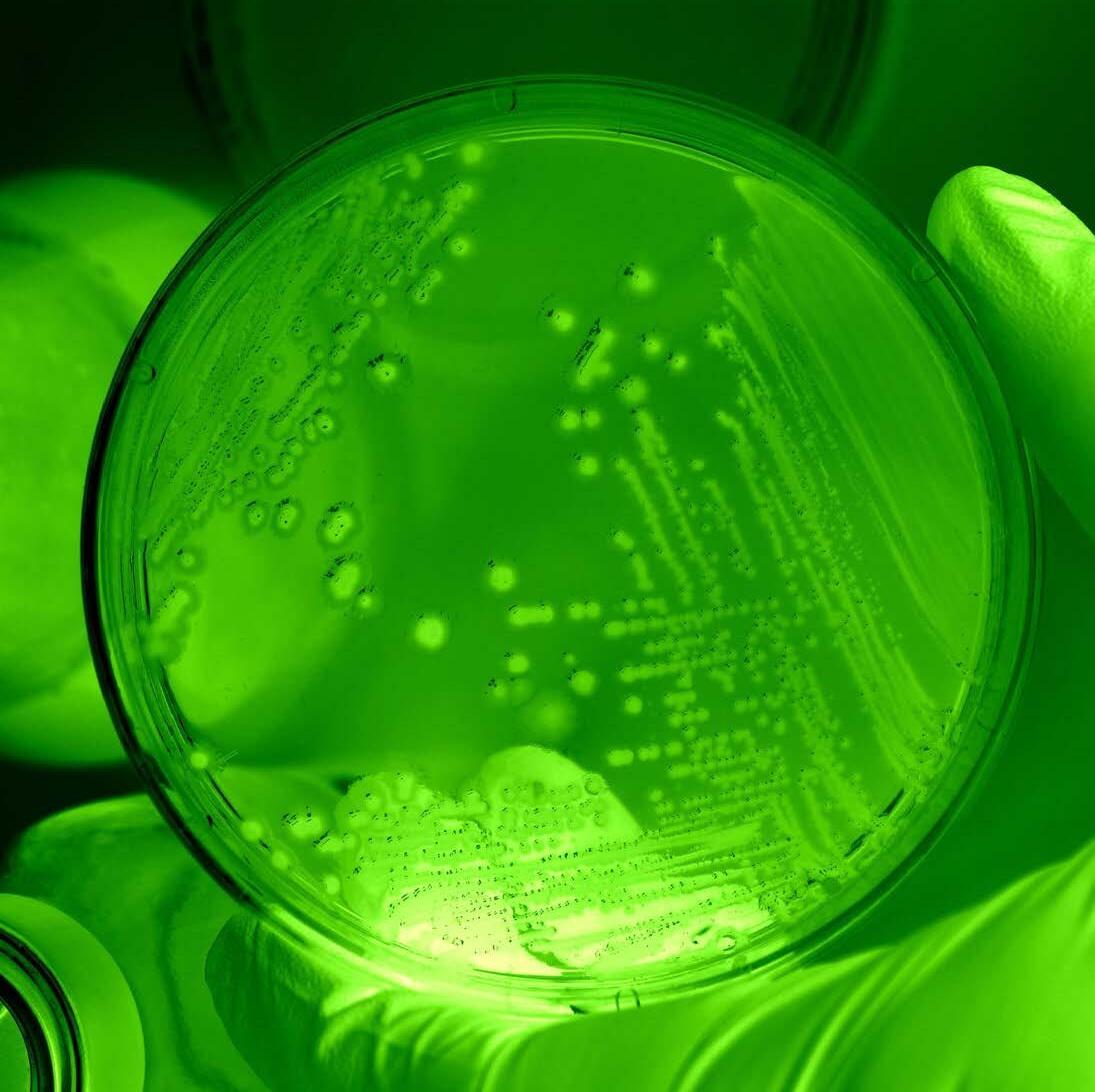

Organisez une démonstration chez vous et nous vous offrirons de 6 à 12 %* !
VOIR PAGE 11


1 cadeau par tranche de 35€ d’achat
VOIR PAGE 12
![]()
Organisez une démonstration chez vous et nous vous offrirons de 6 à 12 %* !
VOIR PAGE 11


1 cadeau par tranche de 35€ d’achat
VOIR PAGE 12
Bienvenue chez Texam Belgique, l’histoire vibrante de notre création est tissée de moments uniques, de rencontres inspirantes, de complicités partagées, de personnes déterminées, de produits exceptionnels, et d’une collaboration fructueuse avec un fournisseur sérieux et innovant. Ces quinze dernières années ont été une aventure passionnante, marquée par des hauts et des bas, mais surtout par la force de notre équipe exceptionnelle de Conseillères et Conseillers.
Aujourd’hui, nous sommes fiers de vous dire que Texam Belgique est toujours là, toujours aussi dynamique. Notre équipe formidable continue de se consacrer à la présentation à domicile, une expérience unique pour vous faire découvrir nos meilleurs produits. Notre engagement premier reste de figurer parmi les meilleurs, de vous offrir des conseils personnalisés, un service irréprochable et de partager des moments agréables avec vous.
Alors, quel est notre objectif pour les prochaines années, demanderez-vous ? Tout simplement, maintenir notre position parmi les leaders, rester à la pointe de l’innovation, et continuer de vous offrir une expérience exceptionnelle. Nous souhaitons demeurer vos Conseillers dévoués, prêts à vous servir et à créer des moments mémorables ensemble.
C’est pourquoi nous tenons à exprimer notre gratitude envers nos Clients et Hôtes, qui nous font confiance depuis le début. Merci infiniment pour votre fidélité. Nous avons hâte de vous retrouver très bientôt pour de nouvelles découvertes et partager encore plus de moments privilégiés.
Chez Texam Belgique, notre priorité éternelle, c’est vous, nos Clients et Hôtes. Merci pour votre confiance renouvelée, et à très bientôt pour cette nouvelle décennie d’aventures passionnantes avec vous.







BIO






LE MEILLEUR DU VÉGÉTAL


Depuis 1996, Texam n’a qu’une obsession ; vous apportez les meilleurs produits professionnels !
Être vos alliés dans votre quotidien en facilitant vos tâches ménagères grâce à une efficacité incomparable !
Le cercle de Sinner, le secret pour ne plus frotter !
CERCLE DE SINNER

Pour un bon nettoyage, 4 éléments entrent en compte.
1. L’action chimique : L’action d’un produit détergent neutre, acide ou alcalin.
2. L’action mécanique : L’action de frotter avec une microfibre, une éponge…
3. La température de l’eau : Elle renforce l’efficacité du produit.
4. Le temps : Il est nécessaire pour laisser le produit agir et retirer facilement les taches tenaces, ou pour qu’un désinfectant inactive un organisme.
Ces 4 éléments sont regroupés en parts égales dans un cercle appelé le Cercle de Sinner.
Si on diminue un de ces facteurs comme l’action chimique, il faudra compenser en frottant plus fort, en laissant agir le produit plus longtemps ou en mettant de l’eau plus chaude.
Chez TEXAM, nous avons fait le choix d’augmenter l’action chimique avec des matières premières nobles et performantes pour proposer des produits professionnels concentrés de grande qualité. Par conséquent, vous gagnez du temps, vous ne frottez plus et vous pouvez nettoyer même en eau froide.

L’EFFICACITÉ MADE IN FRANCE !
LE SAVIEZ-VOUS ?
La conception, la fabrication et l’embouteillage de nos produits liquides sont regroupés sur un même site, celui d’ID Chimie, entreprise filiale de TEXAM, située à moins de 5kms.
Être fabricant de nos produits, c’est :
LA FIERTÉ D’OBTENIR DES PRODUITS MADE IN FRANCE
Cocorico !
L’ENGAGEMENT DE TRAVAILLER AVEC DES SOCIÉTÉS FRANÇAISES :
Nos bouteilles et bouchons viennent du Pas-de-Calais ou de l’Ain, nos cartons et nos étiquettes du Nord, les matières premières de Normandie, nos parfums de Provence !
L’UTILISATION DE MATIÈRES PREMIÈRES NOBLES ET RÉPONDANT
Laisser une terre propre à nos enfants nous anime chaque jour !
FORMULATION DE NOS PRODUITS,
Pour toujours vous apporter les meilleurs produits !

L’ASSURANCE D’UN BILAN CARBONE EXCELLENT !
Contrôle de nos rejets, concentration des produits (moins d’emballages, moins d’eau, moins d’énergie, moins de transport), distance entre Texam et ID chimie (moins de 5km), réutilisation de nos cartons de transport et tellement d’autres choses encore !
Pour vous qui le méritez tellement !


NOBLES ET BIODÉGRADABILITÉ
ULTIME
L’ensemble de nos produits répond à la norme de biodégradabilité ultime. Cette norme oblige un taux de biodégradabilité de 60% en moins de 28 jours.
Chez Texam, l’utilisation de matières premières nobles nous permets d’être bien au-delà de la biodégradabilité minimum dès les 28 premiers jours !
Le reste se décompose, quelques jours ou semaines après.
Grande nouveauté cette année, laissez vous guider par notre nouveau pictogramme !

À gauche : le Naturoscore, il vous indiquera le taux de matières naturelles dans nos produits, en tenant compte de l’eau, des minéraux et des matières premières d’origine végétale.
DES EMBALLAGES RESPONSABLES
Toutes nos microfibres sont désormais emballées dans du papier kraft, 100% naturel, 100% recyclable et 100% biodégradable.
Nos bouteilles sont également faites à partir de plastiques recyclés et sont 100% recyclables
Depuis notre création, nous ne cessons d’améliorer nos formules pour apporter, dès que possible et sans nuire à l’efficacité de nos produits, des matières premières tirées du naturel.
Certains de nos acides sont tirés des minéraux, nos agents de surfaces sont issus de la betterave sucrière (Alkylpolyglucoside), d’huile végétale (glycereth cocoate)…
À droite : le biodégradable score apparu l’année dernière, vous donne la biodégradabilité du produit en 28 jours.
Choisir un produit concentré, c’est une économie sur la durée !
Chez Texam nous concentrons nos produits de manière à en utiliser le moins possible !
Par exemple, grâce à notre concentré de nuages, vous pouvez faire 5 recharges de 500ml de lavant mains… Soit moins de 60 centimes pour 100 lavages !

Nos accessoires et microfibres, c’est la garantie d’avoir des produits qui durent dans le temps.
Acheter un balai Texam fabriqué en Belgique, c’est par exemple 5 ans minimum de durée de vie. En réalité, vous n’achetez pas un balai Texam… Vous investissez dans un balai Texam.

Fini les achats à répétition de balais bas de gamme tous les 6 mois et venant de Chine !
Vous allierez économies et écologie !
!
Deux nouveaux pictogrammes font leur apparition dans le catalogue avec des indications sur la durabilité des produits ou le nombre d’utilisations minimum avec des performances optimales.


Les 2 pictogrammes ci dessus iniquent la durée de nos accessoires, tels que les balais, tapis ou certains aérosols !

Notre pictogramme pour les microfibres, indique le nombre de lavages que vous pouvez effectuer !
Tout ce que vous avez pu lire jusqu’à présent ne pourra jamais remplacer votre Conseiller/ère !
Il/elle sera là pour vous accompagner tout au long de vos achats, vous donner de précieux conseils, répondre à vos attentes… Vous CONSEILLER !
Votre Conseiller/ère vous guide dans la bonne humeur, passe un moment chaleureux avec son Hôtesse et ses Clients, et s’épanoui(e) dans son métier !
Vous travaillerez à votre rythme !
Complément de revenus ou activité temps plein, vous travaillez selon vos envies et vos objectifs !
Vous ne serez jamais seul(e) !
Nos équipes et nos Managers vous accompagne et vous donne les conseils nécessaires pour devenir un(e) Conseiller/ère Professionnel(le) grâce à notre plan de formation !
Aucun investissement de départ !*
Chez Texam, pas d’investissement de départ, vous êtes ici pour gagner de l’argent !
Texam possède le meilleur plan de rémunération de la vente directe !
Complément de revenus ou VRAI métier, avec notre plan de rémunération vous avez le pouvoir d’atteindre rapidement l’indépendance financière !
Alors, vous commencez quand ?
Parlez-en à votre Conseillère/ Conseiller, ou bien contactez-nous sur ! WWW.TEXAM-BELGIQUE.BE *




Être Hôte(sse), recevoir chez soi ses ami(e)s et sa famille, c’est l’assurance de passer un moment convivial et chaleureux !
LA PORTE À VOS AMI(E)S… ILS VOUS DIRONT MERCI !
En ouvrant votre porte, nous pourrons grâce à vous, faire découvrir nos merveilleux produits !
En plus, vos Ami(e)s seront gâtés grâce à notre programme cadeaux !


Pour vous remercier de votre accueil, nous vous offrons 12%* du montant de la vente en produits gratuits sur l’ensemble du catalogue !
Votre Conseiller/ère s’occupe de tout !
Accueillir une démonstration, c’est la garantie d’avoir de précieux conseils de la part de votre Conseiller/ère, de tester les produits, et de sentir nos innombrables parfums !
Alors, la prochaine, c’est pour vous ?
Parlez-en à votre Conseillère/ Conseiller, ou bien contactez-nous sur !
WWW.TEXAM-BELGIQUE.BE

*6% ou 12% si reprise de démonstration.





Éponge métallique
Référence
AZ26

TEXAM VOUS OFFRE UN CADEAU PAR TRANCHE DE 35 EUROS D’ACHAT
DANS CE CATALOGUE. AU CHOIX PARMI LES PRODUITS DE CETTE PAGE.
Eau parfumée*
Références
Câlin de bébé Z9
Cocktail Z6
Douceur perlée Z7
Fraîcheur Z5
Monoï Z12
Néroli Z11
Rêves exotiques Z8
Violette poudrée Z10
Réflexe Ménager* Tous en vente
Références
Amande(6) Réf AP-23
Baie d'açaï(6) Réf AP-21
Bonbon violette Réf AP-20
Citron vert Réf AP-08
Coeur de framboise Réf AP-17
Grenade-hibiscus Réf MV-11
Orangeraie Réf AP-10
Pin des landes Réf AP-02
Pomme Golden Réf AP-12
Désinfectant réfrigérateur* Référence ME17 Stop moisissures* Référence AP04
Désinfect' Fort* Référence AP06G
Pensez à acheter le pulvérisateur professionnel.
* La recharge sans le pulvérisateur. (6) Ne sont pas biocides.
*Offre non cumulable avec les autres offres cadeaux
DEMANDEZ À VOTRE CONSEILLER OU VOTRE CONSEILLÈRE LES CADEAUX DU TRIMESTRE
VENEZ EN PRÉSENTATION
POUR DÉCOUVRIR NOS CADEAUX !
TOUTES LES 10 SEMAINES, 2 NOUVEAUX CADEAUX À 70 EUROS
ET 3 NOUVEAUX CADEAUX À 105 EUROS.


Ce KIT MICROFIBRES contient :
• 1 Éponge multi-usages
• 1 Éponge spéciale vaisselle
• 1 Éponge ronde
• 1 Lot de 2 Essuie-mains
• 1 Torchon vaisselle
• 1 Filet de lavage



(1)(2)(3)
Cette large gamme de lavants sols détergents, désinfectants bactéricides, levuricides et virucides, permet de parfumer agréablement n’importe quels types de sols et surfaces. Ils sont également efficaces sur les virus à enveloppe type coronavirus.
Ces lavants sols surodorants très longue durée peuvent être associés aux SURODORANTS (voir p.37), pour profiter plus longtemps des nombreuses ambiances fleuries et fruitées proposées.
1L = Jusqu’à 50 lavages soit 0.23€ le lavage.

EXISTE EN 5L. Utilisable avec la réf ZPV
VOIR SURODORANTS P.37


(1) Dangereux - respectez les précautions d'emploi.

Biodégradable score 89% 94,72% Naturoscore(4)
(2) Utilisez les biocides avec précaution. Avant toute utilisation, lisez l’étiquette et les informations concernant le produit. (3) Ces lavants sols sont désinfectants bactéricides, levuricides et virucides. (4) Pourcentage de matière d’origine végétale ayant ou n’ayant pas subi de transformation.
Flacon 1l Bidon 5l
Abricot/coco Réf PO-25
Ambiance(3) Réf PO-28 Réf PO-49
Ananas(3) Réf ME-15 Réf PO-53
Citron vert(3) Réf PO-01 Réf PO-41
Cranberry Réf PO-05 Réf PO-71
Fraise(3) Réf PO-35 Réf PO-50
Framboisine(3) Réf ME-11 Réf PO-56
Fruits rouges(3) Réf PO-06 Réf PO-51
Lavande(3) Réf PO-04 Réf PO-44
Monoï(3) Réf EU-71 Réf PO-70
Muguet(3) Réf PO-18 Réf PO-47
Orchidée(3) Réf PO-21 Réf PO-58
Pamplemousse Réf PO-02 Réf PO-42
Pin des Vosges(3) Réf PO-22 Réf PO-60
Poire Réf A15 Réf PO-61
Pomme Réf PO-09 Réf PO-74
Poudre Cocoon Réf EU-73
Rhubarbe/rose Réf PO-66 Réf EU-66
Violette(3) Réf PO-27 Réf PO-48
11,20€
49,55€ (9,91€/L)
Le bon dosage avec le Bouchon doseur p.121

Désinfectants bactéricides, levuricides et virucides
Excellence (1)(2)(3)
SURODORANTS P.36

Découvrez une gamme merveilleuse de lavants sols composée de 9 parfums raffinés et élégants.
Mélanges d’ambiances délicieusement fruitées, sucrées ou sensuelles, ils peuvent être associés pour une présence prolongée, avec les D.D.P.A. TEXAM (voir p.46-47) ou les SURODORANTS EXCELLENCE (voir p.36).
1L = Jusqu’à 50 lavages soit 0.24€ le lavage.
Flacon 1l
Angiola Réf PO-63
Braveheart Réf ME-18
Golden Boy Réf EU-70
Kloros Réf EU-64
Lytéa Réf PO-39
Magnétik Réf PO-65
Victory Réf PO-64
11,60€
(1) Dangereux - respectez les précautions d'emploi. (3) Ces lavants sols sont désinfectants bactéricides, levuricides et virucides. (2) Utilisez les biocides avec précaution. Avant toute utilisation, lisez l’étiquette et les informations concernant le produit.








(4) Pourcentage de matière d’origine végétale ayant ou n’ayant pas subi de transformation.
Spécialement créée pour les 25 ans de TEXAM, cette gamme anniversaire est composée de lavants sols aux odeurs sophistiquées et raffinées. Ils peuvent être associés pour plus de présence encore, aux parfums d’ambiance SURODORANTS 25 ANS (voir p.38).
1 L = jusqu’à 50 lavages soit 0.23€ le lavage.
Flacon 1l
Cosmik Réf PO-76
Crépuscule Réf PO-82
Dark Seduction Réf PO-69
Destinée Bleue Réf PO-75
Femme
ExtraORdinaire Réf PO-57
Indépendante Réf PO-78
Midnight Cherry Réf PO-59
Night Run Réf PO-67
L'Ombre du Rivage Réf PO-79
Soleil Levant Réf PO-68
Terre Mystique Réf PO-77
The Beach Réf PO-80
The Little Rock & Roll Réf PO-81






















Les parfums très rémanents de ces 5 lavants sols, vous apporteront des ambiances harmonieuses de détente et de repos, grâce à des parfums rares et de très haute qualité.
Ils peuvent être associés pour plus de présence encore, aux parfums d’ambiance FEN WEI TEXAM (voir p.49).
1 L = jusqu’à 50 lavages soit 0.26€ le lavage.
1l Le feu Réf A12 La terre Réf A13 12,65€
(1) Dangereux - respectez les précautions d'emploi. (4) Pourcentage de matière d’origine végétale ayant ou n’ayant pas subi de transformation.
Granulés aspirateur
Pour aspirateur avec ou sans sac.
Ces granulés éparpillés sur le sol, une fois aspirés, diffuseront un agréable parfum désodorisant.
Flacon 240g
Marine Réf F2
Menthe/ eucalyptus Réf F7
Contient environ 25 doses

UTILISABLE DANS LE CENDRIER



Le bon dosage avec le Bouchon doseur p.121

Landes(1)
Ce produit très concentré est un puissant dégraissant pour le lavage de tous sols, mais aussi pour l’entretien des sanitaires, cuisines, murs… Il possède une action désodorisante, retire le biofilm et reste actif même en eau calcaire. Utilisé en alternance avec un LAVANT SOLS NET ODEUR TEXAM.
Flacon 1l Bidon 5l
EU-37 9,40€ 41,05€ (8,21€/L)


(1)
Il nettoie en profondeur et ravive les couleurs de vos moquettes et tissus sur les fibres naturelles ou synthétiques. Idéal pour les sièges de voiture. S’utilise à la brosse ou en shampouineuse.
Flacon 1l Réf EU-12 10,95€
Surfaces fragiles et brillantes
(1)
Ce produit nettoie et fait briller les surfaces brillantes telles que parquet flottant, comblanchien, marbre, carrelage, tomette… Il ne laisse aucune trace et permet une réoccupation rapide des locaux.
Flacon 1l Bidon 5l Réf ME-12 Réf EU-55 10,40€ 46,30€ (9,26€/L)
(1) Dangereux - respectez les précautions d'emploi. (4) Pourcentage de matière d’origine végétale ayant ou n’ayant pas subi de transformation.

20 à 25 m² traités en 3 couches
Lave et cire en même temps Liquide décapant
Ce liquide est un puissant décapant, dégraissant alcalin très concentré, qui permet d’éliminer les vieux films de cires, métallisés ou acryliques. Idéal pour la remise en état des sols, il est indispensable pour décaper vos surfaces avant d’appliquer le METALLIC’SOLS et d’obtenir un brillant durable.


Cette cire métallique permet d’obtenir un brillant exceptionnel, comparable à celui des sols des hôpitaux, halls d’aéroports… Décaper au préalable les sols avec le DECAP’SOLS TEXAM, puis passer 3 couches en croisant. Un résultat garanti ! Brillant et sans traces !
Flacon 1l Bidon 5l
(1) Dangereux - respectez les précautions d'emploi. (4) Pourcentage de matière d’origine végétale ayant ou n’ayant pas subi de transformation.
Ce shampooing lave et cire les sols plastiques, dalles PVC et carrelages en donnant un aspect brillant.
À utiliser en alternance avec le NET ODEUR TEXAM, pour redonner un coup de brillance entre deux applications. À utiliser uniquement sur des sols traités.



Bouchons pinces gazes uniques remplaçables
Connectique en S multidirectionnelle facilitant la godille
Grâce à sa boule rotative et la connectique multidirectionnelle en S du support, l'ensemble facilite la technique de la godille. Ce manche en aluminium anodisé avec revêtement en peinture EPOXY apporte une aisance et un confort sans égal dans le balayage ou le nettoyage et une maniabilité exceptionnelle en s’adaptant à votre taille et à chaque type d’utilisation (diamètre 29 mm - jusqu’à 1,80 m de longueur).
Réf B7

Ce support en aluminium anodisé avec revêtement en peinture EPOXY, équipé d’une connectique en S multidirectionnelle brevetée qui facilite la technique de la godille, permet sans effort particulier, le nettoyage des sols. Équipé de bouchons pinces gazes remplaçables pour la fixation des GAZES UNIQUES (voir p.28). Ses nombreuses pièces détachées lui permettent une durée de vie illimitée. Sa largeur est de 40 cm. Il permet également grâce à son système de blocage de nettoyer murs et plafonds avec plus de facilité. Réf B8

Durée de vie exceptionnelle grâce à ses pièces détachées vendues séparément
Réglettes velcro remplaçables (6) En
Réglette pour un aplat parfait de la microfibre





Utilisez vos balais et votre RACLETTE TEXAM sur le manche du BALAI MULTIFONCTIONS TEXAM avec la connectique droite (voir p.31).
Réf ZCOD
2,70€
(5) En respectant les conditions normales de lavage et d’utilisation.
Cette frange microfibre tri composition, tissée en zigzag, permet de laver, dégraisser et récurer. Sa très grande autonomie assure un nettoyage jusqu’à 50 m2 en 1 seule opération. Mise en place rapide sur la monture.
Réf B9 10,10€
séchage ou balayage à sec
Cette frange microfibre bi-composition, tissée en zigzag, permet une absorption parfaite jusqu’à 25 m2 par chacun de ses fils. Mise en place rapide sur la monture.
Réf B10 9,90€
S'adapte sur le manche du BALAI MULTIFONCTIONS pour une utilisation optimale de la serpillière et un résultat parfait.
Réf B15
Système de blocage pour faciliter le nettoyage des plafonds
Forme incurvée pour le nettoyage des plinthes ou frotter les taches
Raclette intégrée pour le nettoyage des joints

La serpillière reste attachée grâce à ses bouchons pince-serpillière


Se fixe sur la monture du BALAI MULTIFONCTIONS. Sa texture avec pointes et alvéoles assure un balayage simple, rapide et efficace. A associer aux GAZES UNIQUES TEXAM.
Réf BG9

Ces gazes imprégnées d’huile minérale sont spécialement conçues pour retenir les poussières, poils... Adaptées sur la monture mousse avec pointes et alvéoles, elles permettent un balayage efficace même dans les joints de carrelages.
Réf BG3
(6) En respectant les conditions normales d’utilisation.

Grand format
Cette serpillière tricotée, fabriquée en France en coton ultra résistant est facile à rincer ou à essorer. Grâce à la finition soignée des coutures, elle ne s’effiloche pas en cas d’accros.
Réf GB-02 8,20€
Cette serpillière microfibre convient parfaitement pour le nettoyage de tous types de sols (carrelages, parquet, linoléum, marbre…). Sa composition et ses propriétés microfibres permettent de capturer la saleté au plus profond du sol. Très fort pouvoir absorbant et essorage facile. Un résultat rapide et sans traces.
Réf EN-29
12,80€
(5) En respectant les conditions normales de lavage et d’utilisation.

Le Balai coiffeur permet de ramasser les cheveux, poils de chiens et chats...
Ses picots en « V » sont plus efficaces que les picots traditionnellement ronds puisqu’ils permettent de produire de l’électricité statique. La raclette située sur le côté du balai vous permet de gratter les tapis ou encore la moquette et se change en cas d’usure. Sa bague est spécialement étudiée pour y adapter tous types de manches. Complètement interchangeable, sa durée de vie est illimitée !
Réf B14
25,80€



Equipée de picots en « V » permettant de produire de l’électricité statique pour ramasser efficacement, la Balayette est très pratique d’utilisation grâce à son manche disposant d’une rotation à 360°.
Idéale pour brosser efficacement canapés, petit tapis, paniers pour animaux, sièges de voiture…
Réf B16
19,40€


Avec sa poignée pouvant pivoter à 360° et sa lame extra fine, cette pelle ramasse efficacement les liquides et les particules les plus fines. Grâce à l’électricité statique produite par le BALAI COIFFEUR ou la BALAYETTE, le résultat est rapide et efficace.
Réf B17
14,40€
(6) En respectant les conditions normales d’utilisation.
Balai intérieur
Réf B1 18,95€

Balai récureur
Réf B2 18,25€

Balai de cantonnier
Réf B3 26,45€

Raclette
Réf B4 21,70€


LES BALAIS ET RACLETTE TEXAM : - RÉSISTANT À +120 ° C - RÉSISTANT AUX ACIDES, ALCALINS ET SOLVANTS - FIBRES À MÉMOIRE DE FORME - CRAMPRONS DE RETENUE DE FIBRES
Ce manche en fibre de verre, ergonomique et renforcé, s'adapte aux balais et raclette TEXAM. Il résiste à 90 kg de pression. Longueur 1.40 m, diamètre : 25 mm.

Microfibre ultra-absorbante


Tapis de sol microfibre (pour l’intérieur)
Ce tapis absorbe jusqu’à 2.4 L/m² et retient les saletés incrustées sous les chaussures ou tombant de l’évier. Sa semelle composée de vinyle, de plastifiant et de caoutchouc recyclé lui permet d’être antidérapante et solidifie les contours. Il ne peluche pas et sèche rapidement. Il existe en 4 formats.


Ce tapis grattant élimine les saletés accumulées sous les chaussures sans abîmer les semelles.
Antidérapant, hydrofuge et très résistant, il ne se déforme pas et dispose d’une grande durée de vie.
Convient pour une utilisation intérieure et extérieure.
Tapis 50 x 80 cm Réf A22

Face grattante grâce à 22 680 ergots

Cet incroyable tapis d’extérieur garde constamment un aspect propre et une efficacité incomparable. Grâce à sa face supérieure composée de 22 680 ergots grattants, il absorbe 1,5 kg de salissures et de poussières. Traité anti UV, anti bactérien, anti-champignons et 100 % recyclable, il se nettoie facilement par simple jet d’eau et ne pourrit pas.
Tapis 45 x 75 cm
Réf A20

Il absorbe 1,5 kg de salissures et poussières

Quelques pulvérisations suffisent pour créer un environnement agréable à la maison, sur le lieu de travail, dans la voiture…
Ces produits peuvent être associés aux LAVANTS SOLS (voir p.16 à 22), pour profiter plus longuement de leurs nombreuses ambiances raffinées, élégantes et sensuelles.
Ils peuvent également s’utiliser avec de l’eau dans les humidificateurs.
Pulvérisateur 250ml
Angiola TC-12
Braveheart TC-17
Diamé TC-15
Forana TC-13
Golden Boy TC-18
Kloros TC-19
Lytéa TC-16
Magnétik TC-20
Victory TC-14
9,95€






































Quelques pulvérisations suffisent pour créer un environnement agréable à la maison, sur le lieu de travail, dans la voiture…
Ces produits peuvent être associés aux LAVANTS SOLS (voir p.16 à 22), pour profiter plus longuement de leurs nombreuses ambiances fleuries et fruitées.
Ils peuvent également s’utiliser avec de l’eau dans les humidificateurs.
Pulvérisateur 250ml
Abricot/coco Réf PO-36
Ambiance Réf PO-31
Ananas Réf PO-20
Citron vert Réf PO-11
Cocktail Réf TC-10
Cranberry Réf PO-24
Florale Réf PO-13
Fraise Réf PO-29
Framboisine Réf PO-32
Fruits rouges Réf PO-17
Lavande Réf PO-38
Lys Réf TC-11
Monoï Réf PO-10
Muguet Réf ME-10
Océane Réf TC-09
Orchidée Réf PO-34
Pamplemousse Réf PO-12
Pêche/abricot Réf PO-33
Poire Réf PO-19
Pomme Réf PO-26
Poudre Cocoon Réf PO-98
Rhubarbe/rose Réf PO-23
Rose cristallisée Réf PO-45
Vanille Réf PO-30
Violette Réf PO-37
9,55€













Également créés pour les 25 ans de TEXAM, quelques pulvérisations de ces SURODORANTS suffisent pour créer un environnement agréable à la maison, sur le lieu de travail, dans la voiture… Ces produits peuvent être associés aux LAVANTS SOLS (voir p.16 à 22), pour profiter plus longuement de leurs nombreuses ambiances fraîches et subtiles.
Ils peuvent également s’utiliser avec de l’eau dans les humidificateurs
Pulvérisateur 250ml
Cosmik Réf PO-89
Crépuscule Réf PO-96
Dark Seduction Réf PO-87
Destinée Bleue Réf PO-88
Femme ExtraORdinaire Réf PO-83
Indépendante Réf PO-91
Midnight Cherry Réf PO-84
Night Run Réf PO-85
L'Ombre du Rivage Réf PO-92
Soleil Levant Réf PO-86
Terre Mystique Réf PO-90
The Beach Réf PO-93
The Little Rock & Roll Réf PO-94
9,55€ VOIR NET ODEUR 25 ANS P.20-21

(1) Dangereux - respectez les précautions d'emploi. (4) Pourcentage de matière d’origine végétale ayant ou n’ayant pas subi de transformation.
Pensez à associer votre parfum d’ambiance au lavant sol correspondant





Fen Wei(1)
Ces parfums d’ambiance très rémanents, permettent d’harmoniser l’énergie dans les lieux de vie (maison, voiture, bureau…). Quelques vaporisations suffisent pour créer une ambiance de confort et de bien-être autour de vous. Ces produits peuvent être associés aux LAVANTS SOLS FEN WEI (voir p.22), pour profiter plus longuement des 5 éléments qui constituent le FENG SHUI.
Pulvérisateur 250ml
Le bois Réf F11
L’eau Réf F10
Le feu Réf F12
Le métal Réf F14
La terre Réf F13




La concentration en matières neutralisantes et la rémanence de son parfum font de ce destructeur, un produit exceptionnel. Il détruit les mauvaises odeurs telles que : odeurs de tabac, de WC, de cuisine, des niches ou paniers d’animaux… Grâce à sa buse « extincteur », une pression d’une seconde suffit pour couvrir 60 m3 ou taper 3 à 4 fois rapidement sur la buse avec le poing. Sans danger pour les textiles. 9 senteurs sont disponibles en aérosols géants.













(1) Dangereux - respectez les précautions d'emploi. (4) Pourcentage de matière d’origine végétale ayant ou n’ayant pas subi de transformation. * Passage au nouveau décor dès rupture de stock.
GAGNEZ-MOI EN ORGANISANT UNE DÉMONSTRATION CHEZ VOUS !


Irremplaçable(1)
Un produit exceptionnel qui détruit les mauvaises odeurs tout en laissant un parfum élégant. Très concentré, très économique, son action dure très longtemps.


Un produit exceptionnel qui détruit instantanément les mauvaises odeurs tout en parfumant agréablement. Il s’utilise à la maison, dans la voiture... Idéal pour combattre les odeurs de cuisine ou de tabac.
Pulvérisateur 250ml
Uniquement en cadeau
(1) Dangereux - respectez les précautions d'emploi. (4) Pourcentage de matière d’origine végétale ayant ou n’ayant pas subi de transformation.
Fleur de pêcher Réf PO-16 Nectar Réf PO-14 9,55€
Une simple pression suffit pour diffuser la bonne dose de parfum
Fixation murale par vis ou adhésif double face (fournis)
PUSH LE BOUTON POUR METTRE L’AMBIANCE !

Cet appareil extrêmement simple d’utilisation, a été conçu spécialement pour recevoir les AEROSOLS PARFUMS D’AMBIANCE TEXAM. Pour le faire fonctionner, il suffit tout simplement d’appuyer sur le haut de l’appareil. Grâce à des bandes adhésives, il s’installe très facilement dans les toilettes ou tout endroit à parfumer mais peut également être vissé. Vendu sans aérosol.
L’appareil
Réf T0
3,80€
Ouverture et fermeture facile avec une clé

Posés sur une étagère pour être nomades ou fixés au mur dans le diffuseur Push parfum, les Aérosols parfums d'ambtiances vous proposent des notes subtiles et fraîches.

Délicieux parfums d’ambiance



Cet aérosol de grande qualité libère d’une simple pression un parfum subtil et très concentré. Il est aussi très économique et procure des centaines d’instants très agréables.

Aérosol 300 ml
Réf T1
Réf T6
Réf T5
Réf T7
Réf T2
10,95€
(1) Dangereux - respectez les précautions d'emploi.

d’Ambiance (1)
Destructeur d’odeurs
Cet aérosol n’est pas comme les autres… En effet, celui-ci libère un parfum menthol de grande qualité, mais détruit également les mauvaises odeurs. Il est aussi très économique et procure des centaines d’instants très agréables.
Aérosol

Ce désodorisant au parfum rare et délicat, inspiré des plus belles compositions odorantes est étonnant. Sa formulation très sèche et concentrée parfume et rafraîchit agréablement tous vos espaces de vie, en quelques pulvérisations. Ce produit n’est pas un destructeur d’odeurs.

(1) Dangereux - respectez les précautions d'emploi.


D.D.P.A.
(Diffuseur Dynamique
Professionnel d’Ambiance)
Cet appareil à poser ou à fixer, trouvera partout sa place grâce à un design élégant et à un choix de capots interchangeables aux divers coloris. Il parfume automatiquement jusqu’à 80 m2. Il fonctionne avec 3 piles LR6. Vous pouvez adapter l’appareil en fonction de vos besoins (temps de pulvérisation et puissance du D.D.P.A., jusqu’à 9 réglages possibles). Livré avec un embout et un cadre interchangeable pour une pulvérisation horizontale ou verticale, sans pile et sans aérosol.
Réf 305
29,90€
Témoin lumineux de l’état de l’appareil Vert : fonctionnement normal Rouge clignotant : aérosol vide Rouge fixe : piles à remplacer.
Sélecteur choix de la fréquence des pulvérisations.
Sélecteur choix de la puissance Min / Med / Max.
Bouton pressoir de déverrouillage du capot.
Arrêt / 7.5 / 15 / 30 min. Bouton poussoir éjection de l'aérosol.
Alimentation : 3 piles LR6 1,5V.
AUTONOMIE DES PILES
6 à 18 mois, variable selon l’intensité de diffusion et le choix de programmation.

(6) En respectant les conditions normales d’utilisation.
D’AMBIANCE S’HABILLENT DE COULEURS GRÂCE À LEURS CAPOTS INTERCHANGEABLES !
Jouez les harmonies et les accords parfaits, personnalisez votre intérieur et tous vos lieux de vie grâce à cette palette de 8 couleurs subtiles et variées.

Ciel Réf 298
Lavande Réf 297
Nuit Réf 299
Orange Réf 294
Rose Réf 295
Rouge Réf 296
Vert anis Réf 293
7,15€
Chromé Réf 300
9,75€
Mode d’emploi pour changement de capot : C’est tout simple. Il suffit de dévisser les 2 vis supérieures et la vis centrale situées à l’intérieur de la coque puis de la remplacer par une autre coque de couleur en ne revissant que la vis centrale (ATTENTION ! La vis centrale est la plus petite des 3).



Tête : Bergamote, prune, pêche
Cœur : Rose, jasmin, iris
Fond : Vanille , ambre, patchouli

Parfum sensuel, fleuri, fruité et ambré, pour créer une ambiance riche et confortable.
Réf 308
12,15€

Tête : Orange, citron, pomme verte, herbe coupée
Cœur : Fève tonka, géranium, lavandin
Fond : Santal, patchouli, vanille, ambre
Note chaude, fruitée et subtile évoquant une ambiance des îles.
Réf 301
12,15€



Tête : Feuille de menthe
Cœur : Menthe glacée
Fond : Menthe sucrée
Savant mélange de menthe et de chlorophylle. Elimine les odeurs de tabac dans des accords frais et verts.
Réf 304
12,15€
AÉROSOLS 150ML POUR D.D.P.A. (1) ÉLÉGANCE ET RÉMANENCE !

Tête : Pomme, pêche, notes vertes
Cœur : Melon, muguet, iris
Fond : Mousse verte

Fragrance à l’allure d’un jardin, mêlant avec succès sorbet fruité et accord fleuri. La pomme et la pêche dominent en tête, puis se fondent peu à peu sur une note melon/muguet/iris avant de s’étendre sur un lit boisé de mousse verte.
Réf 310
12,15€

Tête : Citron, orange, bergamote, cassis
Cœur : Muguet, aubépine, ananas, cocktail de fruits
Fond : Patchouli, vanille, muscs, santal
Instant magnétique où la note fruitée du citron et celle du cassis s’entrecroisent avec la note florale du muguet et du patchouli sur un fond vanillé tendre et poudré pour un parfum féminin subtil et passionné.
Réf 306 12,15€


Tête : Citron, anis, bergamote
Cœur : Géranium, rose, lilas
Fond : Musc, vanille, santal, caramel
Parfum sensuel, doux et heureux, évocation de souvenirs d’Asie. Un merveilleux voyage parfumé au milieu des senteurs enivrantes de rose, de santal et de vanille musquée.
Réf 311
12,15€
(1) Dangereux - respectez les précautions d'emploi. (2) Utilisez les biocides avec précaution. Avant toute utilisation, lisez l’étiquette et les informations concernant le produit. (3) Produit non commercialisé en Belgique.


Tête : Citron, bergamote, eucalyptus
Cœur : Camomille, rose, violette
Fond : Santal, vétiver, mousse, vanille
Un boisé sensuel à la tête fraîche et hespéridée s’ouvre sur un cœur floral poudré pour laisser place à un fond mystérieux ambré et boisé.
Réf 314
12,15€


Tête : Bergamote, orange
Cœur : Jasmin, muguet, aubépine
Fond : Réglisse, cèdre, vanille, muscs


Tête : Citron, badiane, melon
Cœur : Violette, lavande, cèdre
Fond : Santal, vanille, musc
Un parfum viril mais sensuel, fouetté par l’écho vigoureux du citron, avant de trouver les notes de violette et de cèdre offrant une note puissante et chaleureuse, pour finir enfin sur le Santal, la vanille et le musc.
Réf 313 12,15€

Joyeux régal de la nature ! Une ambiance délicieuse de cueillette de fruits des bois où les fruits rouges se font frais, doux et sucrés telle une confiture. Les fleurs s’harmonisent tendrement et se fondent sur une note vanillée.
Réf 309
12,15€
(1) Dangereux - respectez les précautions d'emploi.

Tête : Citron, pamplemousse, ananas
Cœur : Rose, muguet, cannelle, muscade
Fond : Ambre, thym, musc, ciste
En tête, les notes d’agrumes rencontrent l’ananas, laissant la place à une onde florale bercée de rose-muguet aux accents épicés, adoucie par un voile d’ambre et de muscs délicats, et réchauffée par un accord cistethym.
Réf 312
12,15€


99,9%
D’origine naturelle

99,9%
D’origine naturelle
99,9% D’origine naturelle

Détendez-vous !
À partir d’un mélange de 10 huiles essentielles principales rigoureusement sélectionnées pour leurs propriétés anti-stress, calmantes et relaxantes, cette brume d’ambiance incite à la détente et au bien être. 1 à 2 pulvérisations dans la chambre pour préparer une nuit calme et sereine. 1 flacon = 470 pulvérisations.
Pulvérisateur 100ml
Réf SI-24
12,95€

Purifiez votre intérieur
À partir d’un mélange de 9 huiles essentielles principales rigoureusement sélectionnées pour leurs propriétés purifiantes ainsi que pour le bien être qu’elles procurent, cette brume d’ambiance permet de purifier l’air, de chasser les mauvaises odeurs et d'assainir l’atmosphère. 1 flacon = 470 pulvérisations.
Pulvérisateur 100ml
Réf SI-23
12,95€

Tonifiez-vous !
À partir d’un mélange de 10 huiles essentielles principales rigoureusement sélectionnées pour leurs propriétés vivifiantes et dynamisantes, cette brume d’ambiance permet de tonifier l’atmosphère et de stimuler les sens pour retrouver vitalité et dynamisme. 1 flacon = 470 pulvérisations.
Pulvérisateur 100ml
Réf SI-25 12,95€
(1) Dangereux - respectez les précautions d'emploi. (4) Pourcentage de matière d’origine végétale ayant ou n’ayant pas subi de transformation.
Un parfum est composé de plusieurs ingrédients d’origine végétale ou synthétique, c’est ce qui le rend unique.
Pour se donner une image visuelle de la composition d’un parfum, on classe ses notes dans une pyramide olfactive qui se définit selon : la puissance olfactive et le temps (la rémanence) du parfum.


1. Note de tête : C’est la fragrance qui se présente en premier. Constituée à partir d’éléments généralement frais et intenses c’est la note la plus éphémère. Elle va durer quelques minutes voire 1 heure.
2. Note de cœur : La note de cœur est moins vive et remplace la note de tête lorsqu’elle s’estompe. Elle va véhiculer l’identité et la puissance du parfum. On retrouve par exemple des notes fruitées et épicées qui vont durer plusieurs heures.
3. Note de fond : C’est l’odeur la plus persistante. Elle va servir de fixateur aux notes de tête et de cœur, ce qui va permettre au parfum de durer de longues heures, voire plusieurs jours.

Tous les Réflexe peuvent être vendus

Ce produit exceptionnel désinfecte, nettoie et dégraisse toutes les surfaces lavables fragiles ou protégées (grès, terres cuites, linos, sols marbrés, carrelages, inox, émail, surfaces peintes, réfrigérateur…). Il est aussi contact alimentaire et laissera une senteur agréable après son utilisation. Une table à débarrasser et à nettoyer ? Vite, une éponge… et REFLEXE MENAGER ! Nettoyer le plan de travail, le micro-ondes, la plaque de gaz… ? Vite, une éponge… et REFLEXE MENAGER !
À utiliser avec la MICROFIBRE MIRACLE (p.78) ou l’EPONGE MICROFIBRE MULTI USAGES (p.82). De quoi être stupéfait !





Amande(6) Réf AP-23
Baie d'açaï(6) Réf AP-21
REF-12 Bonbon violette Réf AP-20

30 x 30 cm




Idéal pour le nettoyage de votre cuisine, avec sa double face, vous allez pouvoir récurer sans griffer, laver, essuyer et sécher vos surfaces. Il se plie facilement en 4 pour une meilleure prise mains.
Réf EN-35
6,35€

Réfrigérateur et micro-ondes
20 x 14 x 1.2 cm

(2)
grandes surfaces planes ou encore gros ustensiles de cuisine. Sa mousse à mémoire de forme permet une prise en main adaptée, un confort incomparable ainsi qu'une durée de vie allongée.
Réf AZ-25
10,60€
À l’heure où l’on parle de plus en plus de contamination bactérienne, c’est le produit bactéricide parfait pour la désinfection de votre réfrigérateur. C’est également un puissant nettoyant, dégraissant et destructeur d’odeurs agréé contact alimentaire.
Recharge 500ml Bidon 5l
Réf ME-17 Réf EU-35
8,60€ 39,60€ (7,92€/L)
Vous possédez le pulvérisateur professionnel ? Économisez en achetant simplement la recharge.
(2) Utilisez les biocides avec précaution. Avant toute utilisation, lisez l’étiquette et les informations concernant le produit. (4) Pourcentage de matière d’origine végétale ayant ou n’ayant pas subi de transformation. (5) En respectant les







Ce détergent concentré super professionnel élimine instantanément tous les corps gras, facilite le rinçage et le séchage sans aucune trace et apporte une brillance parfaite.
Les tests comparatifs révèlent que 4gr de produit permettent de laver jusqu’à 60 assiettes, faisant de ce produit une véritable révolution. En eau chaude, tiède ou froide, la vaisselle est étincelante, parfaitement dégraissée et sans traces.
Enrichi d’un surgraissant à base de coprah, il garde les mains douces.

Spéciale petites mains



Idéale pour le nettoyage de la vaisselle grâce à sa taille ergonomique. Sa double face permet de récurer sans griffer, laver, essuyer et sécher. Rapide, sans traces et sans peluches. À utiliser avec les produits TEXAM afin d’obtenir un résultat exceptionnel
Réf AZ-28
5,80€
Idéale pour le récurage des couverts, des plats à cuisiner fort encrassés, les planches à découper, les ustensiles de cuisine en bois, en métal non fragile…
Réf AZ-26
Uniquement en cadeau


EXISTE EN 5L.
Utilisable avec la réf ZPV


Ce Gel lave-vaisselle est un puissant détergent et dégraissant. Triple action. Protection du lave-vaisselle, des ustensiles et anti-traces. Ses agents séquestrants protègent votre lavevaisselle contre le calcaire et la corrosion. Ils créent un film protecteur haute brillance autour de vos ustensiles qui les protègent de la corrosion, tout en supprimant les traces d’eau. Ses enzymes dernière génération assurent une efficacité redoutable contre une multitude de substrats. Agréablement parfumé au citron. Jusqu’à 40 lavages soit 0.31cts le lavage.

Pour lave-vaisselle


Cet additif de rinçage concentré pour lavevaisselle permet un séchage rapide et sans traces, afin d’obtenir une vaisselle étincelante. Il est compatible avec toutes les marques de produit lavant la vaisselle.
1l
ME-02
Ce désodorisant lave-vaisselle élimine efficacement les mauvaises odeurs et diffuse pendant plusieurs semaines une agréable senteur citronnée. Efficace pendant environ 60 lavages, il n’imprègne pas la vaisselle et contient un destructeur d’odeurs. À positionner à l’arrière du panier supérieur, grâce à un crochet adapté. 3 doses = jusqu’à 180 lavages.
Lot de 3 doses
Dangereux - respectez les précautions d'emploi.
Pourcentage de matière d’origine végétale ayant ou n’ayant pas subi de transformation.
En respectant les conditions normales de lavage et d’utilisation.

Léger, résistant et antichoc, cet égouttoir révolutionnaire à mémoire de forme protégera efficacement votre vaisselle.
Fini les odeurs, les résidus ou la saleté emprisonnés !
Réf EN-36
23,10€

30 x 40 cm
35 x 50 cm

Idéal pour se sécher les mains. Super absorbants et très doux, ils sont à placer dans la cuisine ou salle de bains et WC.
Lot de 2
Gris Réf MI-29 9,95€
Nouveau coloris

Torchon microfibre
Spécial verrerie
Une brillance exceptionnelle de la verrerie. Ce torchon microfibre vous garantit un essuyage rapide, sans traces et sans peluches.
Réf MI-12
Torchon microfibre
Essuie-verres
C’est le torchon phare des professionnels. Cet essuie-verres possède un très grand pouvoir d’absorption grâce à ses mailles très serrées, ce qui permet un résultat étincelant, sans traces et sans peluches. Idéal pour vos verres précieux, cristal ... 45 x 65 cm

Grâce à sa grande capacité d’absorption ce torchon permet l’essuyage de toute la vaisselle et garantit un résultat sans traces et sans peluches. Gris
(5) En respectant les conditions normales de lavage et d’utilisation.

Nouveau coloris
Acier inoxydable

Lot de 2 tampons inox de 40 grammes en acier inoxydable, très résistants par la qualité de l’acier utilisé. Pour récurer sans rayer les plaques de fours, grilles de barbecues, casseroles... ATTENTION : NE JAMAIS UTILISER L’ÉPONGE À SEC. BIEN SÉPARER LES SPIRES MÉTALLIQUES LORS DU RINÇAGE.
Lot de 2
Réf NI-01
6,80€

Ce produit est idéal pour nettoyer (après dégraissage), rénover et faire briller tous vos supports en inox, chrome et autres surfaces en acier inoxydable. Il élimine les traces d’eau et de calcaire et évite une re-déposition rapide de la poussière grâce à son effet antistatique. Il redonne aux surfaces leur éclat initial !
Aérosol 400ml
Réf SI-04
13,45€

22 x 15 cm
Idéal pour faire briller tous types d’inox. Il convient pour les hottes d’aspiration, les fours, les éviers, les crédences, les plans de travail…
Réf EN-15
8,95€
À utiliser absolument avec le nettoyant inox Texam pour un résultat exceptionnel.
Dangereux - respectez les précautions d'emploi. (5) En respectant les conditions normales de lavage et d’utilisation.


Idéal pour les vitres d’inserts de cheminées
Directement ou par trempage, ce super dégraissant professionnel élimine les graisses de cuisine sur les grilles de cuisson, les filtres des hottes, les barbecues, les fours, les inserts…

NE PAS UTILISER SUR L’ALUMINIUM, LA FONTE, LA FONTE EMAILLEE, LE CUIVRE, UNE SURFACE PEINTE OU VERNIE.
Flacon 500ml Bidon 5l Réf EU-04B Réf EU-31
(1) Dangereux - respectez les précautions d'emploi. (4) Pourcentage de matière d’origine végétale ayant ou n’ayant pas subi de transformation.


Ce produit est idéal pour détartrer vos petits appareils électroménagers, comme votre cafetière, bouilloire...
Lire attentivement la notice de l’appareil ménager avant toute utilisation. Exceptionnel pour blanchir les joints de carrelages avec la BROSSE MULTI-USAGES (voir p.85). Avant utilisation sur les sols, vérifier au préalable la résistance de la surface.
Flacon 500ml
Réf EU-15

Une durée de vie de vos machines prolongée ! Ce produit acide est destiné au détartrage des lave-linges et des lave-vaisselles. Il permet d’attaquer, de décoller et de dissoudre les dépôts de calcaire. 1 traitement par mois, soit 10 mois d’utilisation par flacon rend ce produit très économique.
Flacon 1l
Réf ME-13
0,95€/mois pour l’entretien de vos machines (1) Dangereux - respectez les précautions d'emploi. (4) Pourcentage de

Super dégraissant
Sans traces
Redonne l’aspect brillant de vos plaques

Nettoyant vitrocéramiques & inductions(1)
Ce produit super dégraissant nettoie et élimine les graisses de cuisine sans rayer. Il fera briller vos plaques vitrocéramiques et inductions. Agréé contact alimentaire.
Recharge
Réf 212B 8,10€

1 L = 1,43 kg de produit
à récurer(1)
Grâce à sa poudre de marbre ultra fine, cette crème à récurer nettoie et fait briller toutes les surfaces dures même fragiles telles l’émail, l’inox, la faïence, le stratifié. Sa formule exclusive facilite le rinçage et laisse un agréable parfum. Son pH de 10,5 en fait un alcalin dégraissant. Etudiée spécialement pour les cuisines collectives et pouvant être au contact des denrées alimentaires, elle a sa place dans la cuisine et peut s’utiliser également dans les sanitaires et la salle de bains.
Flacon 1l
Réf A8 11,30€
Vous possédez le pulvérisateur professionnel ? Économisez en achetant simplement la recharge. (1) Dangereux - respectez les précautions d'emploi. (4) Pourcentage de matière d’origine végétale ayant ou n’ayant pas subi de transformation.
Formule écologique

L
Haute résistance
Sacs très résistants. Sa tri composition donne une résistance et une élasticité forte. Les soudures latérales et les liens coulissants tous deux renforcés, garantissent un effet antigoutte, une manipulation facile et une hygiène irréprochable.
Liens coulissants renforcés
Soudures latérales renforcées

Sacs 30l x 15
Sacs 50l x 10 Sacs 100l x 10

À utiliser absolument avec Turbo WC-PLUS !

L’outil WC
L’outil indispensable pour des WC étincelants. Elle permet de chasser l’eau de la cuvette, puis après avoir versé TURBO WC-PLUS TEXAM, de mélanger fortement pour obtenir une mousse abondante à répartir même sous les rebords de la cuvette.
Réf NVA-01
4,90€



NE RENTRE PAS DANS LES CADEAUX À 35€ DE COMMANDE
Indispensable pour ranger la VADROUILLE et le flacon de TURBO WC-PLUS TEXAM. Il permet également un transport aisé. Livré seul.
Réf CV 5,95€

EXISTE EN 5L. Utilisable avec la réf ZPV

Turbo WC-Plus(1)
Un produit super professionnel extraordinaire pour ne pas dire miraculeux. À utiliser, là où tous les autres produits ont échoué. Un résultat surprenant : une cuvette de WC à l’état neuf ! La mousse super active agit immédiatement et détruit le tartre, le calcaire, la rouille et autres dépôts. Il est sans danger pour les fosses septiques et est à utiliser impérativement avec la VADROUILLE WC TEXAM.
Flacon diffuseur 1l Bidon 5l
Réf EU-13 Réf EU-44
51,85€ (10,37€/L)

Idéal en complément de Turbo WC-PLUS !
Gel WC(1)
Voici enfin un gel WC qui nettoie, détartre et désodorise en même temps, sans danger pour les fosses septiques. Répartir le gel sous les rebords et les parois, laisser agir toute la nuit et actionner la chasse d’eau. Idéal en complément journalier du TURBO WC-PLUS TEXAM.
Flacon diffuseur 1l Réf A7


Ces nettoyants parfumés aux senteurs agréables et rémanentes, s’utilisent pour le nettoyage et détartrage de toutes les surfaces sanitaires, telles que les douches, lavabos, robinetteries… Ils suppriment les traces de calcaire, laissent un brillant éclatant et un effet déperlant sur les surfaces traitées tout en parfumant très agréablement.
7,25€ 44,95€
EXISTE EN 5L. Utilisable avec la réf ZPV (1) Dangereux - respectez les précautions d'emploi. (4) Pourcentage de matière d’origine végétale ayant ou n’ayant pas subi de transformation.


Ce nettoyant a été spécialement conçu pour l’entretien régulier des sanitaires, robinetteries et faïences. Il rénove, détartre et fait briller en même temps tout en laissant un agréable parfum. Il dissout la rouille, le calcaire, les dépôts de savon… Sans danger pour l’inox et le chrome car exempt d’acide chlorhydrique.
VOIR CRÈME À RÉCURER. P.61 (1) Dangereux - respectez les précautions d'emploi. (4) Pourcentage de matière d’origine végétale ayant ou n’ayant pas subi de transformation.
NE PAS UTILISER SUR LE MARBRE, LES BAIGNOIRES EN ACIER, ALUMINIUM, FONTE ÉMAILLÉE ET SUR LES PIERRES VIVANTES.
Flacon diffuseur 1l
Réf ME-04
12,50€

Le Détar’Fraich… écologique ! À base d’acide méthane sulfonique, ce détartrant a été conçu spécialement pour être respectueux de l’environnement et s'utilise sur certaines pierres vivantes. Il est important de réaliser au préalable un test sur une surface non visible. Les substances utilisées sont communes de la nature et permettent une biodégradabilité plus rapide.
Flacon diffuseur 1l
Réf H7
14,45€
EN CADEAU POUR 35€ DE COMMANDE VOIR P.12

(2)
Ce produit bactéricide, levuricide (anti moisissures, champignons…) est le produit idéal pour désinfecter, tout en nettoyant toute la salle de bains. Pour éviter et supprimer les moisissures, décaper les joints de carrelage avec la BROSSE MULTI-USAGES (p.85) et le DETAR’FRAICH TEXAM (p.69) puis les pulvériser 1 à 2 fois par semaine.
Recharge 500ml Bidon 5l
Réf AP-04 Réf EU-34
6,55€
30,95€ (6,19€/L)
Vous possédez le pulvérisateur professionnel ? Économisez en achetant simplement la recharge.

Parfumés à la fraise
VOIR AUTRES DIMENSIONS P.64
Sacs très résistants. Sa tri composition donne une résistance et une élasticité forte. Les soudures latérales et les liens coulissants tous deux renforcés garantissent un effet anti goutte, une manipulation facile et une hygiène irréprochable dans votre salle de bains et WC.
Odeur : Fraise.
Sacs 10l x 30 Réf AZ-1
2,60€
(2) Utilisez les biocides avec précaution. Avant toute utilisation, lisez l’étiquette et les informations concernant le produit. (4) Pourcentage de matière d’origine végétale ayant ou n’ayant pas subi de transformation.


Diviser par 10 le temps de nettoyage des vitres c’est possible ! Ce produit allié à la MICROFIBRE ou le GANT SPÉCIAL VITRES TEXAM permet de nettoyer vitres et glaces facilement, de dissoudre instantanément toutes les saletés grasses ou sèches et d’éliminer toutes les salissures d’insectes sans laisser de traces. Il possède une protection antistatique contre les poussières.
Aérosol géant
750ml
Réf EU-11
13,50€

Exceptionnel !
À utiliser avec une microfibre
(1) Dangereux - respectez les précautions d'emploi.

40 x 40 cm


10 ans d’utilisation

Résultat éclatant
Spéciale vitres
Cette microfibre convient parfaitement pour tous types de surfaces vitrées comme les miroirs, les fenêtres, les tables… Elle nettoie et dégraisse en un seul passage ! À utiliser avec le NETTOYANT VITRES TEXAM pour un résultat exceptionnel.
Réf EN-27
8,45€
Spécial vitres
Cet accessoire indispensable pour des vitres étincelantes en un temps record permet de dégraisser et de nettoyer en un seul passage mais aussi d’accéder à des endroits difficiles (coins de fenêtre, pare-brise de voiture…). Une face pour nettoyer ; une face pour sécher rapidement des dizaines de mètres carrés.
Réf AZ4
18,55€
(4) Pourcentage de matière d’origine végétale ayant ou n’ayant pas subi de transformation.
(5) En respectant les conditions normales de lavage et d’utilisation.
Facile d’emploi, cette crème nettoie et dépose un film protecteur et invisible sur vos vitres, glaces, miroirs, chromes, faïences… qui deviennent éclatants et brillent plus longtemps, en résistant mieux aux intempéries et aux marques de doigts. Retrouvez des vitres éclatantes et brillantes plus longtemps grâce à son effet déperlant et antistatique.
NE PAS UTILISER AVEC UNE MICROFIBRE OU UTILISER TOUJOURS LA MÊME.
Flacon 500ml
Réf TC-04 8,40€ Biodégradable
Il permet d’accueillir le Sa composition lui permet d’être très flexible et incassable.
Réf AZ-22 9,95€

La raclette réinventée !
L’innovation réside dans sa flexibilité permettant de racler la vitre de haut en bas sans aucun effet de « sautillement ». À utiliser avec le BRILL’VITRES pour un résultat spectaculaire !
Raclette Vitres Lame de rechange pour raclette
Réf AZ-21 Réf ZRAC 7,60€ 3,30€



Dilué = 1 L pour moins de 0,80€
Compatible avec les nettoyeurs vitres électriques



Issu d’un mélange de solvants et d’agents de surface hyper mouillants, ce produit permet un dégraissage rapide de la vitre, une glisse facile de la raclette et une évaporation immédiate pour un résultat sans traces. Très concentré : 1 L de concentré = 20 L de solution.
Réf EU-72 15,50€
(1) Dangereux - respectez les précautions d'emploi. (4) Pourcentage de matière d’origine végétale ayant ou n’ayant pas subi de transformation.

Il permet de nettoyer et faire briller vos écrans sans laisser de trace. Son effet antistatique évite aux poussières de se redéposer. Utilisable sur écran d’ordinateur, LED, OLED, de smartphones et toutes surfaces en verre fragiles. Idéal pour rendre la brillance de vos plaques vitrocéramiques ou inductions.
Cette microfibre a été spécialement conçue pour le nettoyage des écrans fragiles tels que le plasma ou les écrans LED. Sa douceur incomparable et ses qualités nettoyantes permettent un résultat exceptionnel. À utiliser avec le NETTOYANT ÉCRANS TEXAM.


Grâce à sa formule innovante, ce produit évite la présence de buée sur toutes surfaces vitrées (vitres, miroirs…). Une fois appliqué sur la surface, il vous garantit un résultat surprenant durant 5 à 10 jours. Recharge
Vous possédez le pulvérisateur professionnel ? Économisez en achetant simplement la recharge.

Nettoyer sans frotter

Nouveaux coloris

(1)
Ce produit nettoie et dégraisse tout seul. Il suffit de vaporiser sa mousse active qui agit par capillarité et d’assister au miracle ! Elle va rechercher et faire remonter à la surface les salissures et la graisse. Il n’y a plus qu’à essuyer, sans frotter. Idéal pour traiter l’aluminium anodisé ou peint, l’inox, les chromes, les faïences, les stratifiés, les plastiques, le simili cuir, le PVC…
Aérosol géant 750ml
Réf A6 13,10€
40 x 40 cm
Lot de 2 microfibres
Grâce à sa composition spécialement étudiée pour nettoyer efficacement toutes les graisses, poussières…, cette microfibre permet une utilisation sur tous types de surfaces pour un résultat rapide, sans traces et sans peluches.
Lot de 2 microfibres
Réf MI-15 13,40€
(1) Dangereux - respectez les précautions d'emploi. (5) En respectant les conditions normales de lavage et d’utilisation.

Sans alcool et pourtant comme l’alcool ! Ce produit s’évapore très rapidement pour ne laisser aucune trace. Il est idéal pour nettoyer remarquablement les surfaces modernes stratifiées, peintes ou plastiques, tout en laissant une sensation de neuf au toucher. Il élimine également les traces de certains stylos et feutres.
Recharge 500ml Bidon 5l
Il nettoie les salissures tenaces, grasses ou anciennes sur toutes surfaces lavables, peinture, émail, stratifié, matière plastique...
Recharge 500ml Bidon 5l


EXISTE EN 5L. Utilisable avec la réf ZPV
Vous possédez le pulvérisateur professionnel ? Économisez en achetant simplement la recharge.
(1) Dangereux - respectez les précautions d'emploi. (2) Utilisez les biocides avec précaution. Avant toute utilisation, lisez l’étiquette et les informations concernant le produit. (4) Pourcentage de matière d’origine végétale ayant ou n’ayant pas subi de transformation.
Ce produit est un puissant bactéricide et levuricide pour désinfecter toilettes, poubelles extérieures et intérieures et tous lieux où apporter une hygiène irréprochable est nécessaire. Il laissera une odeur agréable de pin des landes. Recharge


Dilué = 500 ml pour moins de 0,75€
Nettoie Tout(1)
Ce produit est utilisé pour le lessivage des murs, peintures, salissures tenaces et toutes surfaces, y compris les pièces mécaniques grasses. Il suffit d’y verser 50 ml de produit puis de le remplir d’eau. Vous obtenez 20 flacons/pulvérisateurs prêts à l’emploi. Soit moins de 0.75 € le flacon de 500 ml. Idéal pour la rénovation des salons de jardins, piscines extérieures…
Recharge 1l Bidon 5l
Réf EU-03B Réf EU-36
13,60€ 59,05€ (11,81€/L)

(1)





Ce produit indispensable lubrifie, dégrippe, combat l’humidité, nettoie et protège. Neutre, sans silicone, il s’utilise sur tous les matériaux et s’adapte à tous les besoins : auto, moto, vélo, usage ménager (serrure, charnière…), jardin, chasse, bricolage, nautisme…
Aérosol 200ml
Réf SI-12 8,20€
Cette éponge est idéale pour tous les gros travaux de la vie quotidienne. Sa double composition permet de dégraisser les surfaces en profondeur, d’éliminer les salissures même les plus tenaces, sans rayer (face grattante), et de sécher sans laisser de trace (face absorbante). Résultat rapide, sans traces et sans peluches.
Réf EN-33
7,60€
(1) Dangereux - respectez les précautions d'emploi. (2) Utilisez les biocides avec précaution. Avant toute utilisation, lisez l’étiquette et les informations concernant le produit. (3) Produit non commercialisé en Belgique. (4) Pourcentage de matière d’origine végétale ayant ou n’ayant pas subi de transformation.
VENEZ DÉCOUVRIR TOUTES LES 10 SEMAINES NOS NOUVEAUX COLORIS !

Idéale pour le nettoyage de tous types de surfaces, cuisine, salle de bains ... Sa double face permet de récurer sans griffer, laver, essuyer et sécher. Rapide, sans traces et sans peluches ! À utiliser avec les produits TEXAM afin d’obtenir un résultat exceptionnel. Leur forme ronde et leur élastique réversible sur les deux faces assurent une meilleure prise en main.
x 11 x 2,5 cm
Multi-usages
Idéale pour le nettoyage de toutes les surfaces. Sa double face permet de récurer sans griffer, laver, essuyer et sécher. Rapide, sans traces et sans peluches ! À utiliser avec les produits TEXAM afin d’obtenir un résultat exceptionnel.
Grise Réf MI-19
Diamètre : 14 cm.



Grise Réf AZ-27 6,10€

VENEZ DÉCOUVRIR TOUTES LES 10 SEMAINES
Diamètre : 14 cm


Ce gant est idéal pour le dépoussiérage et le nettoyage de toutes les surfaces. Ses fibres longues lui permettent d’accéder au moindre recoin même sur des surfaces à relief. Très épais, il protège bien la main et bénéficie d’un grand pouvoir d’absorbtion. Pour un résultat rapide, sans traces et sans peluches.
(5) En respectant les conditions normales de lavage et d’utilisation.
Le bon produit c’est bien, avec la bonne microfibre c’est encore mieux !
Il en existe de différentes formes, textures… Au final ce qui ne change pas dans une microfibre, c’est sa composition à partir de fibres synthétiques. Les plus utilisées sont le polyester et le polyamide.
La combinaison des deux va apporter de la résistance à la microfibre et lui permettre d’absorber les graisses, l’eau et aussi de dépoussiérer facilement toutes les surfaces.

Deux choses vont principalement différencier les microfibres : leur grammage et la structure du tissu.
La structure du tissu va dépendre de l’usage de la microfibre, lavage des surfaces, essuyage des mains, dépoussiérage, nettoyage des écrans…


Il faut savoir que les fibres d’une microfibre sont 100 fois plus petites qu’un cheveu et qu’il faut au minimum 10 km de fibres pour fabriquer 1 g de tissu.
Chez TEXAM, nous sommes aux environs de 40 km de fil pour 1 g de tissu, avec un grammage moyen de 320 g au mètre carré ! Des gages de qualité qui vont permettre à nos microfibres d’avoir des résultats impeccables à sec ou avec un produit.



TISSU SUÉDÉ
Applications
Surfaces lisses et fragiles : écrans plats, verrerie, optique…
Correspondances
Microfibre lunettes, Microfibre écrans
TISSU TRICOTÉ PLAT OU CIRCULAIRE
Applications
Surfaces vitrées
Correspondances
Gant vitres, Microfibre spéciale vitres
TISSU TRICOTÉ BOUCLETTES COURTES
Applications
Surfaces à relief
Correspondances
Microfibres miracle, éponges
TISSU TRICOTÉ BOUCLETTES
LONGUES TRESSÉES
Applications
Surfaces à relief
Correspondances
Franges de lavage (sec ou humide)
TISSU FIBRES LONGUES ET RASÉES
Applications
Surfaces à relief
Correspondances
Gant voiture, Gant multi-usages
Idéale pour le nettoyage des joints de carrelage (cuisine, salle de bains…) en combinaison avec le DETAR’FRAICH (voir p.69) et/ou les SANIS TEXAM (voir p.68), cette brosse peut également être utilisée sur textiles, sièges de voiture, nettoyage des ongles… Idéale pour blanchir les joints de carrelage sols avec le DÉTARTRANT ALIMENTAIRE (voir p.62).
7,20€

Très légères
Très ergonomiques
Très résistantes

9,95€

(6) En respectant les conditions normales d’utilisation.
Grâce à son grand pouvoir nettoyant, BEL’LUNETTES TEXAM rend de l’éclat à toutes les lunettes !
Aérosol 75ml
Réf SI-17 8,10€

12 x 20 cm
Ne raye pas
Ne peluche pas
Simple, pratique, à la taille idéale, voici une vraie microfibre pour nettoyer les lunettes en un « clin d’œil » ! Elle s’utilise en complément du BEL’LUNETTES TEXAM.
Réf EN-14 3,50€
(1) Dangereux - respectez les précautions d'emploi. (5) En respectant les conditions normales de lavage et d’utilisation.


La vraie cire d’antan ! Son parfum antiquaire, sa cire d’abeille et sa facilité d’utilisation en font le produit par excellence pour entretenir et faire briller les meubles anciens ou restés à l’état brut.
Aérosol
Réf SI-02


Il ravive, fait briller, redonne l’aspect du neuf aux meubles massifs, modernes, vernis rustiques, marbres. Il possède une protection antistatique contre les poussières. Plus de 690 g de produit pour une année d’utilisation en moyenne. À NE PAS APPLIQUER SUR LES MEUBLES SCANDINAVES.
Idéale pour toutes les surfaces et les meubles. Son côté fibres longues permet de capter la poussière. Son côté structuré permet de faire briller ou d’appliquer la REFLET ou la CIRE MEUBLES CLAIRS.
MI-13
Conçu pour l’entretien de tous types de cuir, il redonne l’aspect d’origine sans teinter. Il nourrit, assouplit, protège et nettoie le cuir sans laisser de trace.
Réf SI-22


Adaptable sur le MANCHON A MEMOIRE DE FORME pour une prise en main sans utilisation du BALAI MULTIFONCTIONS.

Idéal pour les fauteuils et canapés
Idéal pour les chaussures

Idéal pour les manteaux et sacs à main

Se plie à toutes les formes, des milliers de difficiles d’accès.
Un dépoussiérage rapide, sans traces ni peluches. S’adapte sur le MANCHON (vendu séparément).

Ce produit concentré en matières acides est idéal pour le décapage en profondeur des cuivres, laitons, bronzes… Il retire les traces, l’oxydation, le vert-de-gris et prépare le support à recevoir le POLISH’CUIVRE.
NE PAS APPLIQUER SUR LES CUIVRES VERNIS OU AVEC UN FILM PROTECTEUR.



(4) Pourcentage de matière d’origine végétale ayant ou n’ayant pas subi de transformation.



Le bon dosage avec le Bouchon doseur p.121

EXISTE EN 5L. Utilisable avec la réf ZPV



Cet additif, renforçant de prélavage, par sa formule extra concentrée, permet un nettoyage en profondeur des tissus souillés de taches alimentaires, cambouis… Bien imprégner les taches et les endroits sales. Laisser agir quelques instants puis laver les vêtements. Pour une utilisation optimale, utiliser le ROLL ON (voir p. 128).
Flacon 1l Bidon 5l Réf ME-14 Réf EU-46

IDÉAL POUR LES MOQUETTES ET TAPIS PARFAIT POUR LES SIÈGES DE VOITURES
Utilisable sur les moquettes
Utilisable sur les sièges de voitures
Ce produit élimine bon nombre de taches comme le cambouis, le maquillage, les taches alimentaires… et peut servir aussi à détacher la moquette. Agiter vigoureusement l’aérosol, pulvériser à 20 cm environ, bien imprégner les taches et les endroits sales. Laisser agir quelques minutes puis laver la surface ou les vêtements.
Aérosol 400ml Réf SI-07
(1) Dangereux - respectez les précautions d'emploi. (4) Pourcentage de matière d’origine végétale ayant ou n’ayant pas subi de transformation.

EXISTE EN 3KGS


Adieu la grisaille ! Cette poudre blanche à base de percarbonate de soude rend le linge exceptionnellement éclatant grâce à son fort pouvoir anticalcaire et à sa production d’oxygène actif. L’effet de blanchiment obtenu est bien meilleur que celui de la javel. S’utilise également pour les couleurs, même foncées, sans effet néfaste.
Jusqu’à 33 lavages soit 0.39€ le lavage.
Seau de 1kg Seau de 3kgs
Réf ME-09

Il fixe la couleur sur le linge et évite le transfert des couleurs foncées sur les couleurs claires. Il protège contre le ternissement des couleurs vives et la décoloration des textiles foncés ou noirs. Après un premier lavage de chaque couleur séparément, il est possible de mélanger toutes les couleurs sans aucun danger. Elles restent vives et nettes très longtemps. Pour plus de 60 lavages.
(1) Dangereux - respectez les précautions d'emploi. (4) Pourcentage de matière d’origine végétale ayant ou n’ayant pas subi de transformation. (7) Selon arrivage.

vêtements délicats lors du lavage en machine. Sa composition offre une excellente circulation de l’eau, préserve l’intégrité des tissus en évitant les accrocs et les déformations.
- Fabriquée en France -
Produits professionnels d’hygiène et d’entretien au service des particuliers

embalagem ou o rótulo à mão. P102 : Manter fora do alcance das crianças. P264 : Lavar bem as mãos após manuseamento. P273 Evitar a libertação para o

Pour laines et textiles délicats
N’oubliez pas ! Les produits ménagers c’est toujours hors de portée des enfants

Ce liquide rose, très concentré, au parfum floral très rémanent, a été spécialement conçu pour le lavage à la main ou en machine de tous les lainages et textiles délicats. Rend le linge souple et doux.
Flacon 1l Bidon 5l
Savant mélange de 16 ingrédients dont 6 enzymes, cette lessive sous forme de poudre atomisée vous donnera des résultats exceptionnels !
Action détachante dès 30°c, anti-grisaillement, blancheur du linge préservée, anti odeurs, très concentrée et très économique ; 45g pour une lessive, cette boite de 2.6kg vous permettra d’effectuer 57 lavages !
Carton de 2.6kgs
(1) Dangereux - respectez les précautions d'emploi. (4) Pourcentage de matière d’origine végétale ayant ou n’ayant pas subi de transformation.



Une lessive exceptionnelle pour le blanc comme pour la couleur qui facilite le repassage tout en parfumant subtilement le linge. Très économique, elle lave parfaitement votre linge délicat et laisse un parfum très agréable.
1 L = jusqu’à 25 lavages soit 0.31€ le lavage.
Flacon 1l Bidon 5l


Conçue spécialement pour prendre soin de tous les vêtements noirs ou foncés, la LESSIVE BLACK est composée de 7 enzymes permettant d’éliminer tous types de taches comme le colorant alimentaire, l’herbe, la sauce tomate, et même le chocolat ! En plus de ses performances anti-grisaillement, de donner des couleurs foncées plus intenses et de son efficacité, elle laisse un parfum agréable et rémanent.
1 L = jusqu’à 25 lavages soit 0.34€ le lavage.
NE TEINT PAS LE LINGE.
Flacon 1l Bidon

EXISTE EN 5L. Utilisable avec la réf ZPV








Ce produit très concentré rend le linge doux, souple, moelleux, facilite le repassage, ôte l’électricité statique et conserve au linge ses qualités hydrophiles. Son parfum très rémanent offre une fraîcheur formidable. Très économique, il deviendra vite votre produit fétiche. 1L = jusqu’à 25 lavages soit entre 0.28€ et 0.30€ le lavage (selon la référence choisie).
Cocktail Réf EU-23 Réf EU-30C
Douceur perlée Réf ME-20 Réf EU-57
Fraîcheur Réf EU-21 Réf EU-30F
Rêves exotiques Réf ME-21 Réf EU-58 Violette poudrée Réf EU-14 Réf EU-30V 6,95€
(6,26€/L)
Le bon dosage avec le Bouchon doseur p.121 20ml (1) Dangereux - respectez les précautions d'emploi. (4) Pourcentage de matière d’origine végétale ayant ou n’ayant pas subi de transformation.

Ce produit, anti-plis, évite le froissement du linge lors du lavage et de l’essorage. Il permet un repassage plus facile. Il est possible également d’en verser 5 bouchons dans un vaporisateur de 500 ml rempli d’eau pour humidifier le linge lors du repassage, ceci afin d’éviter plus facilement les faux plis. Pour plus de 60 lavages.
Flacon 500ml
Réf ME-27



Facilite le repassage EN CADEAU POUR 35€ DE COMMANDE VOIR P.12

Ce produit très concentré ôte les faux plis et facilite le repassage. Son parfum très rémanent prolongera encore plus longtemps les fragrances de vos ASSOUPLISSANTS.
Flacon 500ml
Câlin de bébé Réf Z9
Cocktail Réf Z6
Douceur perlée Réf Z7
Fraîcheur Réf Z5
Monoï Réf Z12
Néroli Réf Z11
Rêves exotiques Réf Z8
Violette poudrée Réf Z10
Uniquement en cadeau
À utiliser de préférence avec un pulvérisateur professionnel.
(4) Pourcentage de matière d’origine végétale ayant ou n’ayant pas subi de transformation.


Ce produit imperméabilise toutes sortes de tissus comme la laine, le coton, les fibres synthétiques, le cuir. Il s’utilise également pour l’ameublement, la bagagerie, la maroquinerie, les intérieurs de voiture… et protège contre les taches de sébum.
22 x 14 cm
Idéal pour le brossage des vêtements, il permet de retirer peluches, cheveux, poils des animaux accrochés aux manteaux, vestes, jupes, pantalons… Un résultat rapide et sans peluches. Réf EN-23
(1) Dangereux - respectez les précautions d'emploi. (2) Utilisez les biocides avec précaution. Avant toute utilisation, lisez l’étiquette et les informations concernant le produit. (5) En respectant les conditions normales de lavage et d’utilisation.


Idéal pour lutter contre les odeurs désagréables tout au long de la journée, ce produit désodorise les pieds, rafraîchit et crée une agréable sensation de bien-être. Pulvériser à 15 cm de la peau.
150ml
Réf SI-15
8,90€

Le Spray Froid apporte un soulagement immédiat après un choc ou un effort. Il est indispensable à tout sportif ou pour soulager votre petit casse-cou lors de ses jeux… Pulvériser à 10 cm de la partie du corps à traiter, en prenant soin d’arrêter la pulvérisation dès l’apparition du givre.
Aérosol 150ml
Réf SI-13
8,35€

Spray Peau, formulé à base d’huiles essentielles, présente des vertus calmantes et apaisantes. Il est idéal pour apaiser les rougeurs et tiraillements des peaux sensibles à l’origine de sensation d’inconfort. Indispensable dans une trousse de secours !
Aérosol 75ml
Réf SI-18
8,10€
(1) Dangereux - respectez les précautions d'emploi. (2) Utilisez les biocides avec précaution. Avant toute utilisation, lisez l’étiquette et les informations concernant le produit.


Entrez dans un monde de pureté et de douceur ! Très concentré, ce savon nettoie en profondeur, laisse les mains très douces, ôte les mauvaises odeurs et parfume agréablement.
Distributeur 500ml Bidon 5l


EXISTE EN 5L. Utilisable avec la réf ZPV
Grâce à ce gel aux solvants abrasifs et agents lavants d’origine naturelle, vous retrouverez de belles mains instantanément. Sa composition à base de roche volcanique permet d’éliminer le cambouis, de nettoyer les mains les plus sales, souillées et encrassées par l’huile de vidange, les graisses, les peintures, les encres...



Ce lavant mains concentré nettoie et hydrate en profondeur la peau tout en laissant une agréable odeur de cassis. Sa formule d’origine végétale et minérale à 98.5 % est enrichie en huile de jojoba, thé vert, guarana et verveine pour garder une peau douce et agréable. Sans sulfate, il convient aux mains sensibles. A utiliser absolument avec le distributeur de savon GUS. Vous versez 100 ml de concentré et complétez avec 400 ml d’eau. Très économique, 1 flacon vous permet d’avoir 5 recharges de 500 ml (soit 2.40 € les 500ml).
Le distributeur de savon GUS, avec son design épuré, trouvera facilement sa place dans votre salle de bains, votre cuisine, vos toilettes… Il délivre une mousse onctueuse et aérienne à chaque pression. Il est à utiliser avec le CONCENTRE DE NUAGES. Ensemble, vous allez pouvoir faire jusqu’à 400 lavages de mains pour 500 ml (à raison de 2 doses par lavage).
Recharge concentré de nuages 500ml

1 concentré de nuages = 5 recharges de gus = 2 000 lavages de mains
100 lavages pour 0,60 €
(1) Dangereux - respectez les précautions d'emploi. (4) Pourcentage de matière d’origine végétale ayant ou n’ayant pas subi de transformation.
COUPEZ L’HERBE SOUS LE PIED AUX MAUVAISES ODEURS

Voici le traitement idéal et efficace contre les odeurs de pieds ! Le résultat étant obtenu au maximum lors du deuxième bain de pieds, il est même garanti « satisfait ou remboursé ». C’est l’engagement TEXAM dans les cas où vous ne seriez pas pleinement satisfait.
6 flacons de 125g + 1 vaporisateur de 50ml
H6
3 mois de traitement Effet garanti satisfait ou remboursé 1 vaporisateur de 50 ml



Ce produit extraordinaire nettoie rapidement pare-brises, pare-chocs, optiques de phares de tous les véhicules. Ne pas utiliser sur des matières brutes (aluminium, fer…) et ne pas mettre dans le liquide lave-glace. Son concentré super actif dissout instantanément le sang séché des insectes écrasés sur votre voiture. À employer avant lavage. Rincer absolument après emploi.
Recharge 500ml Bidon 5l Réf EU-22B Réf EU-48
7,95€ 51,10€ (10,22€/L)
Vous possédez le pulvérisateur professionnel ? Économisez en achetant simplement la recharge.
(1) Dangereux - respectez les précautions d'emploi.


EXISTE EN 5L. Utilisable avec la réf ZPV 22 x 14 cm

Ce shampooing lave et ravive les couleurs. Autoséchant et anticalcaire, il ne laisse aucune trace. La cire qu’il contient laisse un film protecteur et durable qui favorise le ruissellement de l’eau de pluie. Votre véhicule sera toujours impeccable !
Bidon 1l Réf EU-24 11,35€
Spécial automobile
Ce gant est idéal à sec pour le dépoussiérage intérieur du véhicule et pour le lustrage de la carrosserie extérieure. Humide, il nettoie et shampouine la carrosserie. Un résultat rapide, sans traces et sans peluches. A utiliser avec SHAMP’AUTO TEXAM.
Réf EN-26
9,80€
(4) Pourcentage de matière d’origine végétale ayant ou n’ayant pas subi de transformation.
(5) En respectant les conditions normales de lavage et d’utilisation.

Il nettoie, protège, lustre et fait briller sans laisser de trace. Sa composition laisse un film protecteur sur la carrosserie évitant la redépositon des salissures, et offrant un effet déperlant longue durée. Économique, 5 à 7 voitures lavées selon le modèle.
Formule écologique et sans eau ! ATTENTION : NE PAS UTILISER SUR UN VÉHICULE TROP ENCRASSÉ ET SUR UNE CARROSSERIE TROP CHAUDE.
Recharge 500ml
Réf SA-05B
10,90€
Vous possédez le pulvérisateur professionnel ? Économisez en achetant simplement la recharge.

Il ravive les couleurs du plastique sans laisser de film gras et évite la redéposition des poussières grâce à son effet anti statique. Utilisable sur tous types de supports intérieurs ou extérieurs. Laisse une odeur agréable légèrement citronnée.
Recharge 500ml
Réf SA-04B 13,95€
Vous possédez le pulvérisateur professionnel ? Économisez en achetant simplement la recharge.

Redonne l’aspect du neuf aux pneus et permet une brillance longue durée grâce à son agent anti redéposition. Application à la microfibre. Pour un résultat précis utiliser un pinceau. S’UTILISE UNIQUEMENT SUR LE FLANC DES VÉHICULES À 4 ROUES.
Tube 300ml
Réf SA-06 11,20€
(1) Dangereux - respectez les précautions d'emploi. (4) Pourcentage de matière d’origine végétale ayant ou n’ayant pas subi de transformation.

Spéciale automobile
Exceptionnelle pour le polissage des véhicules. Ses longues fibres permettent une application simple du POLISH’AUTO. Utiliser une face pour appliquer et une autre pour lustrer. Très absorbante elle peut être utilisée pour sécher le véhicule.
LAVER UNE FOIS AVANT UTILISATION.

(1) Dangereux - respectez les précautions d'emploi. (4) Pourcentage de matière d’origine végétale ayant ou n’ayant pas subi de transformation. (5) En respectant les conditions normales de lavage et d’utilisation.

Polish’auto(1)
Il rend la brillance aux véhicules et ravive les couleurs. À base d’abrasif et de cire de silicone, il évite la redéposition des salissures, permet un effet déperlant longue durée, et efface les micros rayures. Application à la main ou à la polisseuse.

EXISTE EN 5L. Utilisable avec la réf ZPV


26 x 14 cm


Il nettoie et fait briller les jantes des véhicules sans effort, sans frotter. Ce produit miracle, sans acide, est capable d’éliminer toutes les traces (cambouis, résidus de plaquettes de freins…).
NE PAS UTILISER SUR DES JANTES RAYÉES ET NONVERNIES.
Recharge 500ml Bidon 5l
Réf SA-01B Réf EU-49 9,95€ 64,10€ (12,82€/L)
Vous possédez le pulvérisateur professionnel ? Économisez en achetant simplement la recharge.
Ce gant est idéal pour le nettoyage des jantes des véhicules. Il dispose d’une face grattante bi-composition pour débarrasser les jantes de toutes les salissures sans provoquer la moindre rayure et d’une face bleue permettant un rinçage généreux, et après essorage, un séchage rapide et impeccable. Un résultat rapide, sans traces et sans peluches. À utiliser avec le NET'JANTES
EN-32

(1) Dangereux - respectez les précautions d'emploi. (4) Pourcentage de matière d’origine végétale ayant ou n’ayant pas subi de transformation. (5) En respectant les conditions normales de lavage et d’utilisation.






Il permet le dégivrage efficace et rapide de tous les éléments exposés au gel comme les pare-brise, les serrures, les joints de portes ou de coffre… Contact alimentaire, il convient également pour vos congélateurs, freezer…
Recharge 500ml Bidon 5l
La double composition de cette éponge permet de retirer la buée sur le pare-brise avec la peau de chamois microfibre et de le sécher avec la microfibre bouclette. Un résultat rapide, sans traces et sans peluches.
Réf MI-14 6,95€
Vous possédez le pulvérisateur professionnel ? Économisez en achetant simplement la recharge.
(1) Dangereux - respectez les précautions d'emploi. (4) Pourcentage de matière d’origine végétale ayant ou n’ayant pas subi de transformation. (5) En respectant les conditions normales de lavage et d’utilisation.

Ce produit nettoie et fait briller les plastiques des voitures (tableaux de bord, garnitures, parechocs…) tout en laissant un parfum citronné très agréable. Grâce à son fort pouvoir antistatique, il retarde la redéposition de la poussière.
Aérosol 250ml Réf SI-09 8,90€
La gamme biologique TEXAM, issue de la biotechnologie et complètement biodégradable, se compose de bactéries non pathogènes. Les formulations en micro-organismes apportent une réponse idéale aux problèmes liés aux mauvaises odeurs, à l’engorgement des canalisations, puisards, fosses septiques, fosses toutes eaux…
Leur action est préventive et curative. Bien mieux que des enzymes, ce sont des bactéries qui produisent ellesmêmes des enzymes pour liquéfier la matière et pour mieux l’absorber. Elles se multiplient par 2 toutes les 25 minutes et deviennent plus de 400 millions en moins de 8 heures. Tous ces produits peuvent s’utiliser de manière simultanée.

Biodégradable
Naturoscore(4) (4) Pourcentage de matière d’origine végétale ayant ou n’ayant pas subi de transformation.
NE RENTRE
PAS DANS LES CADEAUX À 35€ DE COMMANDE

Ce produit à base de bactéries biologiques détruit les mauvaises odeurs sur les tissus et textiles, mais également sur d’autres supports comme les litières, niches, panières, poubelles…
Recharge 500ml
Réf A4-B
7,80€
Vous possédez le pulvérisateur professionnel ? Économisez en achetant simplement la recharge.

Ce produit élimine les mauvaises odeurs qui remontent des canalisations. Son action est immédiate. Il est idéal pour la salle de bains car il délite les cheveux et le savon, facilite les écoulements et évite l’obstruction des canalisations. Il est à utiliser 1 à 3 fois/semaine selon l’intensité des odeurs, le soir de préférence, pour une efficacité optimale. Comptage bactérien : environ 40 milliards de bactéries/litre.
Flacon difuseur 1l
Réf A3
14,95€

6 mois de traitement
Voici 6 mois de traitement biologique efficace des fosses septiques ou des fosses toutes eaux. L’ensemble du système de collecte des eaux usées et les matières fécales sont traités en évitant les remontées d’odeurs et les engorgements. Ce produit est idéal pour réensemencer et accélérer la biodégradation des rejets. Il détruit la matière et la cellulose (papier toilette). Proposé en pastilles effervescentes pratiques et économiques. Comptage bactérien : 20 millions/gramme soit 400 millions de bactéries par pastille.
Boîte de 12 pastilles effervescentes
Réf A01
25,50€

Voici 8 mois de traitement de choc pour les bacs à graisses, puisards, regards, drains, canalisations et fosses toutes eaux ! Ce produit supprime les amas graisseux et les odeurs, nettoie complètement toutes les canalisations en découpant et en assimilant les lipides, régénère la flore bactérienne. Présenté en sachets hydrosolubles à diluer dans 3 litres d’eau et à verser dans toutes les canalisations, il est à utiliser 1 fois/mois, le soir de préférence, pour une efficacité optimale. Comptage bactérien : 200 millions/gramme soit 14 milliards de bactéries par sachet.
Boîte de 8 sachets hydrosolubles
Réf A2
35,90€
(1) Dangereux - respectez les précautions d'emploi. (4) Pourcentage de matière d’origine végétale ayant ou n’ayant pas subi de transformation.

Depuis plusieurs années, la préservation de la nature est de plus en plus présente dans nos esprits. Notre façon de consommer a évolué vers des produits plus responsables.
TEXAM n’a pas attendu cette prise de conscience pour concevoir et distribuer des produits allant dans ce sens.
En 2007, une politique d’assainissement sur l’ensemble de la gamme a été mise en place.
Les matières premières « pétrolières » ont commencé petit à petit à laisser place à des matières premières d’origine végétale et renouvelables(1).
Par la suite, TEXAM a décidé de sortir en 2024 deux nouvelles gammes : Le Meilleur du végétal et Eco-
Conception
La volonté derrière ces dernières est de proposer des produits professionnels efficaces, avec des matières premières recyclées ou d’origine végétale, renouvelables et durables(1).
Des critères stricts ont été établis dès le début, afin de garder cette ligne de conduite et de proposer des produits en raccord avec notre temps :
• Produits à base de matières premières renouvelables et d’origine végétale(1)
• Sans allergènes
• Sans pictogramme de danger(2)
• Sans composés corrosifs pour l’homme ni toxique (ou très toxiques) pour l’environnement classés selon la réglementation CLP 1272/2008
• Utilisation de matières recyclées pour la gamme
• Eco-conception
Prendre soin de la nature, c’est commencer par faire attention à chaque geste que nous faisons au quotidien. Cela passe par l’utilisation de produits plus responsables pour la planète et pour soi.

Le bon dosage avec le Bouchon doseur p.121




EXISTE EN 5L. Utilisable avec la réf ZPV
Ces Lavants sols parfument agréablement et durant de longues heures et s’appliquent sur n’importe quels types de surfaces (carrelage, linoléum, parquets flottants…).
Flacon 1l Bidon 5l
Corail Réf MV-01 Réf MV-16
Cranberry Réf MV-06 Réf MV-15
Pomme Réf MV-07 Réf MV-20
(10,58€/L)
Cette serpillière convient parfaitement pour le nettoyage de tous types de sols, carrelage, parquet, linoléum… Sa composition lui permet de capturer la saleté au plus profond du sol. Elle est ultra absorbante et très résistante, pour un résultat impeccable.
Réf EC-02 12, 80€
(5) En respectant les conditions normales de lavage et d’utilisation.
2 bouteilles recyclées

50 x 60 cm


Balayez à base de 100% de plastique recyclé grâce à ce balai !
Sa monture est faite de bouteilles plastiques récupérées en mer, de bouteilles recyclées et de plastique post production. Les fibres à partir de bouteilles recyclées.
Ces fibres à mémoire de forme résistent aux hautes températures et aux acides, alcalins ou solvant.
Réf EC-05

Ce manche en fibre de verre, ergonomique et renforcé, s’adapte aux balais et raclette TEXAM. Il résiste à 90 kg de pression. Longueur 1.40 m, diamètre : 25 mm.
Réf B6

EN CADEAU POUR 35€ DE COMMANDE
VOIR P.12

Le bon dosage avec le Bouchon doseur p.121

Dilué à 10 % = 500 ml pour 0,72€

EXISTE EN 5L. Utilisable avec la réf ZPV
Ce produit exceptionnel est indispensable chez soi ! Il nettoie et dégraisse toutes les surfaces lavables fragiles ou protégées (grès, terres cuites, linos, sols marbrés…) Il est aussi contact alimentaire et laissera une senteur agréable après son utilisation.
Une table à débarrasser et à nettoyer ? Vite, une éponge… et REFLEXE MENAGER ! Nettoyer le plan de travail, le micro-ondes, la plaque de gaz… ? Vite, une éponge… et REFLEXE MENAGER !
Recharge 500ml
Réf MV-11
6,45€
Ce nettoyant dégraissant concentré est à diluer de 3 à 10% selon le degré de salissures. Il permet de nettoyer et dégraisser tous types de taches dans la cuisine. Agréé contact alimentaire, il s’utilise sur n’importe quels supports sans les altérer (aluminium, inox…) et laissera une agréable odeur de citron.
Flacon 1l Bidon 5l
Réf MV-10 Réf MV-17
14,40€ 59,70€ (11,94€/L)



Ce détergent concentré super professionnel élimine instantanément tous les corps gras, facilite le rinçage et le séchage sans aucune trace et apporte une brillance parfaite. En eau chaude, tiède ou froide, la vaisselle est parfaitement dégraissée et sans traces. Enrichi d’un surgraissant à base de coprah et de glycérine, il garde les mains douces.
40 x 80 cm
Grâce à sa grande capacité d’absorption ce torchon permet l’essuyage de toute la vaisselle et garantit un résultat sans traces et sans peluches.
3 bouteilles recyclées
(5) En respectant les conditions normales de lavage et d’utilisation.


À utiliser avec le Détar’Fraich Écologique
Ce nettoyant agréablement parfumé à l’orange s’utilise pour le dégraissage, le nettoyage et le détartrage de toutes les surfaces sanitaires, telles que les douches, les lavabos, les robinetteries… Il supprime les traces de calcaire, laisse un brillant éclatant et un effet déperlant sur les surfaces. Recharge 500ml



Ce produit décolle et dissout tous types de traces sur les vitres, fênetres, miroirs, surfaces en verre… Il laissera une surface brillante et impeccable. A utiliser avec la MICROFIBRE SPECIALE VITRES pour un meilleur résultat.
Recharge 500ml Bidon 5l
Réf MV-03 Réf MV-13 4,90€
EXISTE EN 5L. Utilisable avec la réf ZPV 1 bouteille recyclée
tous types de surfaces vitrées comme les miroirs, les fenêtres, les tables… Elle nettoie et dégraisse en un seul passage ! À utiliser avec le NET‘VITRES pour un résultat exceptionnel.
Réf EC-04 8,45€
(5) En respectant les conditions normales de lavage et d’utilisation.


Dilué à 10 % = 500 ml pour 0,72€ 40 x 40 cm


Ce produit universel est un puissant nettoyant dégraissant. Sa composition augmente son pouvoir nettoyant et lui permet d’être efficace même en eau très dure. A utiliser pour le nettoyage des pièces mécaniques, salons de jardin, carrosseries, lessivage des murs… Très économique, vous pouvez le diluer dans le pulvérisateur vendu séparément. En diluant le produit à 10 %, vous pouvez faire 20 flacons de 500 ml prêts à l’emploi. Soit 0,72 € le flacon de 500 ml.
Idéales pour nettoyer, dépoussiérer ou dégraisser tous types de surfaces.
Elles peuvent s’utiliser humides ou à sec et offrent un résultat rapide, sans traces et sans peluches.
Lot de 2 microfibres
Réf EC-03
2 bouteilles recyclées pour le lot

EXISTE EN 5L. Utilisable avec la réf ZPV
Ce puissant nettoyant dégraissant prêt à l’emploi s’utilise sur des surfaces métalliques résistantes, des murs, des matériaux synthétiques… et permet d’éliminer les taches de graisses, d’huiles, de stylos et autres taches tenaces. Il est aussi idéal pour remettre en état le matériel stocké en hiver comme les tables et les chaises de jardin.
Recharge 500 ml Bidon 5l
MV-09
Le bon dosage avec le Bouchon doseur p.121

Sans classification et sans pictogramme

Une lessive exceptionnelle, la seule sans pictogramme ! Elle convient à tous types de linge, blanc, couleur, textiles modernes et délicats. Elle lave parfaitement le linge tout en laissant un agréable parfum.

* Selon le règlement 2023\1545 modifiant le règlement (CE) no 1223/2009 du Parlement européen et du Conseil en ce qui concerne la mention de substances parfumantes allergisantes sur l’étiquette des produits cosmétiques.


Flacon à remplir de RENFORÇANT AVANT LAVAGE (voir p.92). Sa bille permet de déposer celui-ci et de mieux pénétrer dans les mailles du linge.
Réf ECR
1,55€
Ce pulvérisateur professionnel s’adapte sur les flacons de 500 ml. Il vous assurera des milliers d’utilisations. Sa buse est réglable pour vaporiser en jet ou en brouillard. Une excellente prise en main.
Têtes de pulvérisateur PRO
Bleu Réf PCB
Jaune Réf PCJ
Orange Réf PCO
Rose Réf PCR
Rouge Réf PCP
Transparent Réf PCT
Vert Réf PCV
Violet Réf PCL 0,85€ Flacon 500 ml + pompe


Ces gants de ménage professionnels résistent aux produits acides et alcalins. Avec leur matière en latex naturel et leur intérieur en coton suédé, la sensation de toucher est préservée. Ceux-ci ne sont pas hypoallergéniques.
Gants de ménage
Taille XS Réf AZ24XS
Taille S Réf AZ24S
Taille M Réf AZ24M
Taille L Réf AZ24L 2,90€




Simple d’utilisation, un simple mouvement du poignet vous permet de délivrer une dose de 20 ml facilitant ainsi le dosage de vos produits. économie garantie.
Bouchon Doseur
Bleu Réf BBL
Vert Réf BVE
Violet Réf BVI
2,80€
Cet article est adaptable sur les bidons de 5 litres (réf ZPV) ou sur le bidon d’1 litre du (réf ZPVG).
1 pression = 20 ml.
Réf ZPV Réf ZPVG 2,00€ 2,00€
NE RENTRE PAS DANS LES CADEAUX À 35€ DE COMMANDE





TEXAM INTERNATIONAL (FRANCE)
17, rue Charles Petit
BP 70056
59612 FOURMIES Cedex
Tél : 00 33 (0)3 27 56 16 00 www.texamfrance.fr

TEXAM BELGIQUE 96, rue Haute
B 5060 TAMINES
Tél : 00 32 (0) 477 299 553
00 32 (0) 476 388 568 00 32 (0) 472 886 666 www.texam-belgique.be


TEXAM PORTUGAL
Av Central 2287 4935-574
Castelo do Neiva - Portugal
Tel : +351 919 20 20 50 www.texamportugal.com

TEXAM ITALIA www.texam-italia.it